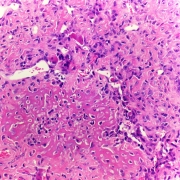

Stammzellspender werden – was heisst das eigentlich?
Etwa 35.000 Menschen jährlich bekommen in Deutschland die Schock-Diagnose Leukämie – so auch Alexander. Oft stehen die Heilungschancen gut – wenn ein passender Spender rechtzeitig gefunden wird. Alexander hatte Glück und will nun weitere Lebensretter rekrutieren. Dazu engagiert er sich bei „AIAS“, einem Verein, der mehr Studenten für die Knochenmarkspenderdatei registrieren will. Und hier ist seine Geschichte.
Wer sich mit dem Gedanken befasst, sich als Blutstammzellspender zu registrieren, wird mit vielen Fragen konfrontiert: Erfülle ich alle Kriterien? Was passiert, wenn es zur Spende kommt? Was geschieht nach der Spende?
Werden Sie aktiv, informieren Sie sich: www.blutspende.ch
Weitere Links:
Die wichtigsten Fragen und deren Antworten rund um die Stammzell- oder Knochenmarkspende finden Sie hier: Alles auf einen Blick.
Hier finden Sie weitere Details: www.blutspende.ch